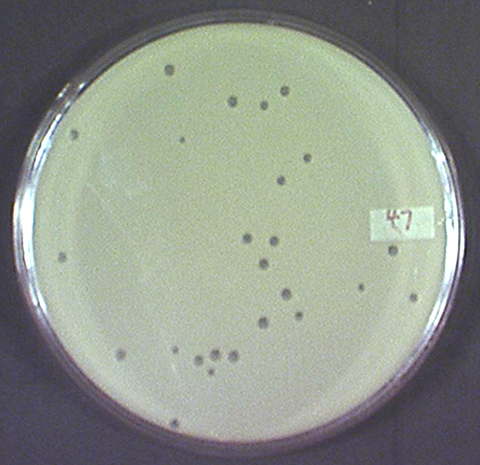

Род Erwinia: бактериальные культуры под микроскопом
















































.JPG)

Раздел: Другие животные